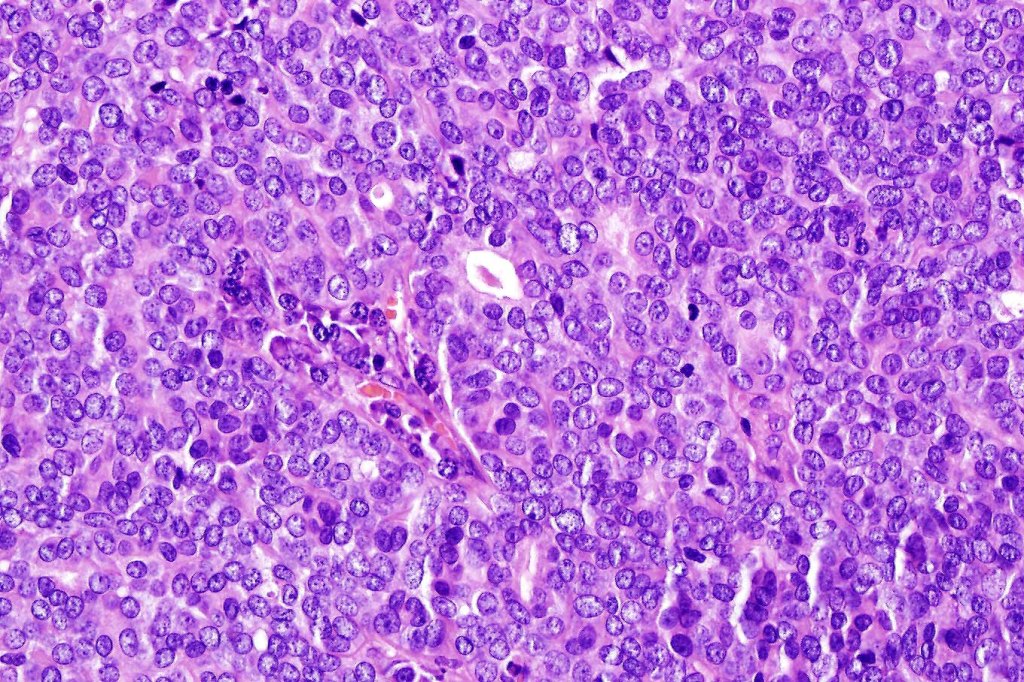

Rare sweat gland carcinoma which may be confused with a papillary metastasis and should be differentiated from papillary eccrine adenoma. Recently has been shown to be associated with HPV42 in the majority of cases Leiendecker et al 2023). A small subset is associated with mutations in BRAF V600E.
Clinical features
•Very rare, often aggressive
•Volar fingers, toes much less often palmar/plantar skin
•Rarely presents at extra-digital sites
•Adults (50-70, median 52 years)
•4-9M:1F
•1-several cm slowly growing, sometimes painful nodule
•Recurrences (30%), distant metastases (14-25%)- lymph nodes & lung, low overall mortality (<3%)
Histological features
•Strong association with HPV42 (Leiendecker et al, 2023)(clinically more aggressive, high-grade morphology, p16+ve), subset associated with BRAF V600E mutation (low-grade histology, p16-ve)
•Frequently circumscribed solid/cystic dermal nodule, infiltrative margin rare
•More advanced tumor can extend into subcutaneous fat, muscle & bone
•Papillary component (may include pseuopapillae & true papillae with a fibrovascular core)
•Back-to-back glands with double-layered epithelium
•Cuboidal/columnar with eosinophilic cytoplasm & vesicular nuclei
•Variable clear cell change & foci of squamous differentiation
•Exceptional decapitation secretion
•Variable pleomorphism & mitotic activity (can appear deceptively bland)
•Often dense, hyalinized collagenous stroma
•Variable necrosis & lymphovascular invasion
•Pankeratin, CK7, EMA & CEA +ve, variable p16+ve
.Myoepithelial cells p63, SMA, calponin & S100 +ve

Differential diagnosis
In the majority of cases, digital papillary adenocarcinoma is easily recognised even at scanning magnification. Very exceptionally, a metastasis from a visceral papillary carcinoma must be excluded. Clinicopathological correlation should resolve the matter. Where doubt remains, identification of a myoepithelial layer and CK7 expression will confirm the diagnosis. Some cases can appear deceptively bland and papillary eccrine adenoma may have to be excluded. Again clinicopathological correlation is valuable as is the identification of true papillae, nuclear pleommorpism and excessive mitotic activity.
Leave a comment